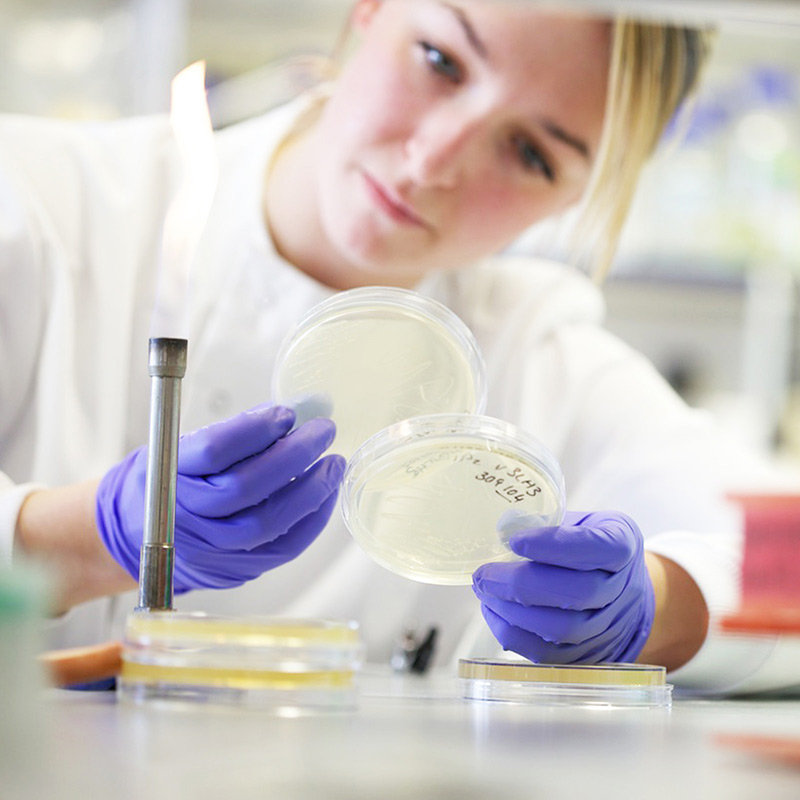
Image of technician working in a lab

Customer Profiling
Customer profiling is a tool we use to better understand the motivations and behaviour of your customers and to help inform your marketing strategy. It is one of the most powerful tools available to marketers today and crucial for creating data-driven customer personas. We use many profiling techniques, which can incorporate multiple data points to generate meaningful customer profiles. Generally, we use internal first party data as well as third party data available commercially such as Mosaic from Experian and Acorn from CACI. As we are agnostic to the actual data used, we provide impartial advice and analysis of which customer profile will best meet the needs of your organisation.
Looking for something else?
Explore our work
Close window-
-
Advertising
-
Audience Segmentation
-
B2B and Trade Marketing
-
Brand Activation
-
Brand Identity and Design
-
Brand Purpose and Positioning
-
Customer Profiling
-
Customer Relationship Marketing (CRM)
-
Data Analytics and Insight
-
Data Compliance
-
Data Exploration
-
Data Management
-
Data Marketing Strategy
-
Data Science & Predictive Modelling
-
Digital Content Creation
-
Digital Design
-
Digital Marketing Strategy
-
Direct Marketing
-
E-Commerce Strategy
-
Email Marketing
-
Employee Engagement
-
Events and Sponsorship
-
Experiential and Field Marketing
-
Influencer Activity and Brand Ambassadors
-
Integrated Marketing
-
Marketing Automation
-
Marketing Strategy
-
Packaging Design
-
Partnership Marketing
-
PPC
-
PR
-
Print Production and Management
-
Research and Insight
-
Sales Promotion
-
SEO
-
Social Media
-
TV and Video Production
-
User Experience Design
-
Web Analytics and Measurement
-
Web Development
-
Website Maintenance and Hosting
-
-
-
Aberdeen University | RGU
-
Baxters Food Group
-
Children's Hearings Scotland
-
Choose a Challenge
-
Cigna Global Health Insurance
-
Cycling Scotland
-
Digital World
-
Dumfries and Galloway College
-
Eric Liddell
-
Food Standards Scotland
-
Growers Garden
-
Historic Environment Scotland
-
Len's Self Storage
-
Loch Ness by Jacobite
-
Matthew Algie
-
National Library of Scotland
-
Oriam
-
Playlist for Life
-
Police Scotland
-
Road Safety Scotland
-
SAMH
-
schuh
-
Scotland Food & Drink
-
Scottish Development International
-
Scottish Fire & Rescue Service
-
Scottish Government
-
Scottish Government | Parent Club
-
Scottish Widows
-
ScottishPower
-
Seychelles Tourism Board
-
Sight Scotland Veterans
-
Simon Howie
-
Skyscanner
-
SNBTS
-
SSDA
-
Sterling Furniture
-
Stoats
-
STV
-
The Dalmore
-
Traffic Scotland
-
VisitScotland
-
Worldwide Cancer Research
-
Zero Waste Scotland
-